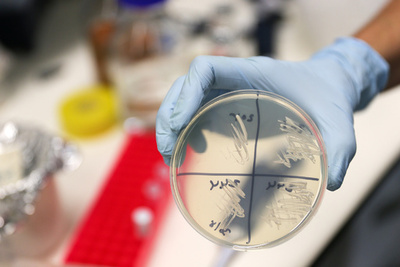
地球最古、10億年前の菌類発見 従来の認識塗り替えるか

環境・科学
-

マレーシア、輸入プラごみ数百トンを返送へ
-

「言語の起源」解明の手掛かり、オナガザルの実験で明らかに
-

真っ白な野生パンダ、カメラが捉える 中国・四川
-

再導入されたヒグマ、馬を殺す「異常な捕食行動」 ピレネー山脈
-

ボツワナ、ゾウの狩猟禁止措置を解除 環境保護団体も賛否分かれる
-

ノルウェーで養殖サケが1万トンも大量死、藻類の開花が原因
-

メキシコ沿岸部に海藻が大量漂着、地元住民が不休で除去
-

スペースX、衛星60基の打ち上げに成功 衛星インターネット計画「スターリンク」
-

NASA、有人月面着陸計画「アルテミス」のスケジュール発表
-

海洋プランクトン、地球温暖化で北上 独研究
-

ファラオも飲んでた? 古代ビールを当時の酵母で再現 「味は最高」 研究
-

地球最古、10億年前の菌類発見 従来の認識塗り替えるか
-

条約で禁止のオゾン層破壊ガス、中国北東部で大量放出 研究
-

朝鮮半島で40年前に絶滅したトキ、野生に放鳥 韓国
-

今世紀末までに海面上昇2メートル、1億8000万人が家失う? 国連予測の倍
-

ボノボの母親、息子の恋人探しの「お助け役」に 研究
-

【今日の1枚】「海の生き物」たちが路上で抗議
-

海岸に漂着したプラごみは「氷山の一角」 実際量を過小評価か 研究